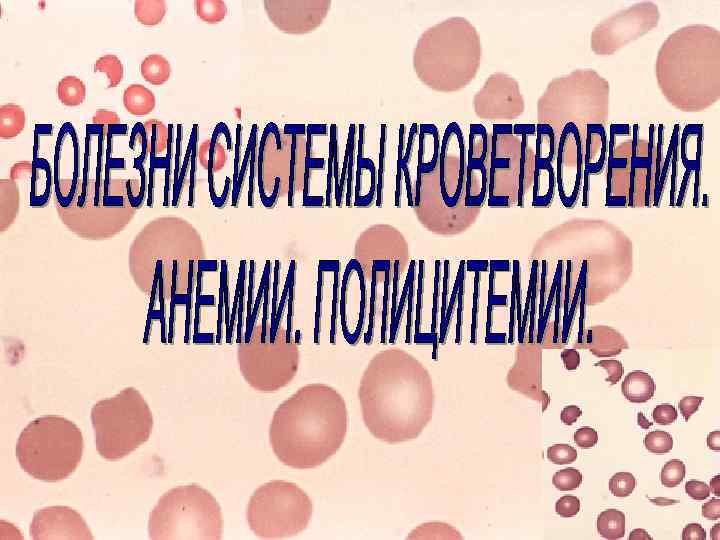
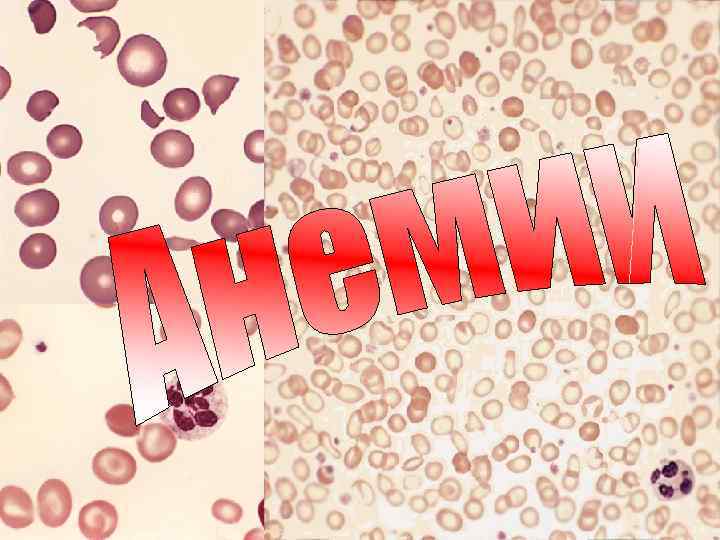

анемии лекц.18.ppt
- Количество слайдов: 64

Патология системы крови включает в себя патологию миелоидной и лимфоидной тканей. Последние гистогенетически едины (родоначальной клеткой являетсястволовая клетка костного мозга). В процессе нормальной дифференцировки стволовых клеток лимфоидное направление "отделяется" первым. Лимфоидные клетки заселяют тимус и периферические лимфоидные органы, несколько обособляясь таким образом в структурном и функциональном отношении от центрального органа гемо- и лимфопоэза - костного мозга. Поэтому патология миелоидной и лимфоидной тканей часто рассматривается раздельно. В то же время система кроветворения и лимфопоэза едина, что обеспечивается общими гуморальными механизмами регуляции клеточной пролиферации и дифференцировки, а также рециркуляцией клеток.

Рециркуляция означает постоянный обмен клеточными элементами между кровью и тканями (гемопоэтическими и лимфоидными, с одной стороны, и периферическими - с другой). Наиболее подробно этот процесс описан для лимфоидных клеток. В ходе кроветворения и лимфопоэза в периферическую кровь выходят преимущественно зрелые (дифференцированные) клетки. В небольших количествах в крови можно обнаружить и незрелые, в том числе стволовые, клетки.

Как и во всех тканях с преимущественно клеточным типом физиологической регенерации, при различных патологических состояниях в костном мозге илимфоидных органах в первую очередь наблюдаются изменения клеточного состава тканей (уменьшение или увеличение количества клеток определенного типа нарушение их взаимного расположения и зонального распределения) и иногда (при наследственных болезнях, диспластических состояниях и опухолях) – изменение структуры клеток. Изменение (увеличение и уменьшение) числа клеток определенного типа (ростка кроветворения) с изменением соотношения зрелых и незрелых клеток обозначают соответственно как гипер- или гипорегенераторный сдвиг гемопоэза. При гиперрегенераторном сдвиге повышается относительное содержание незрелых клеток, а при гипорегенераторном- зрелых.

Анемией (малокровием) называется снижение содержания гемоглобина в единице объема крови. Часто (за исключением железодефицитных состояний и некоторых наследственных аномалий эритроцитов) анемия сопровождается снижением и числа эритроцитов в единице объема крови. В большинстве наблюдений анемия представляет собой проявление какого-либо другого заболевания, поэтому строгая нозологическая классификация анемий невозможна

Вследствие снижения продукции эритроцитов (дисэритропоэтические) мегалобластные, а(гипо)пластические анемии. Вследствие усиления гемолиза (кроверазрушения) или кровотечения (гемолитические и постгеморрагические анемии)

иммунологически обусловленный (аутоиммунные, изоиммунные, гемолитические анемии) связанный с наследственными аномалиями мембран, ферментов эритроцитов или гемоглобина, которые в конечном итоге обусловливают усиленное разрушение клеток. Также наблюдается при токсических и лекарственных воздействиях, травмах, инфекциях, механических влияниях на клетки (искусственные клапаны, длительная ходьба), гиперспленизме (смешанные гемолитические анемии).

Эти анемии связаны с быстрой потерей значительного объема крови. Макроскопически обнаруживают бледность кожи и внутренних органов. Паренхиматозные органы дряблые, иногда с желтоватым оттенком (исчерченностью). Костный мозг губчатых и трубчатых костей ярко-красный, сочный. При гемолитических анемиях органы приобретают желтую (желтуха) или буроватую (гемосидероз) окраску. Микроскопически при всех анемиях, связанных с потерей зрелых эритроидных клеток из крови, наблюдается гиперрегенераторный сдвиг эритропоэза. Объем гемопоэтического костного мозга увеличен и не соответствует возрасту пациента: отмечаются гиперплазия костного мозга губчатых костей и превращение жирового (желтого) костного мозга трубчатых костей в красный. В некоторых случаях можно обнаружить и очаги внекостномозгового (экстрамедуллярного) кроветворения в селезенке и вокруг сосудов. В периферической крови отмечается высокое содержание ретикулоцитов. Постоянно выявляются обусловленные тканевой гипоксией дистрофические изменения миокарда, печени, почек и головного мозга. В миокарде и печени дистрофия может иметь жировой характер. При постгеморрагических анемиях размеры и форма эритроидных клеток периферической крови и костного мозга не меняются, в периферической крови количество ретикулоцитов может достигать15%. Изменения при острой постгеморрагической анемии выражены сильнее, чем при хронической.

Рис. 1. Костный мозг при анемии. Костный мозг трубчатой кости ярко-красный, сочный.

Рис. 2. Внекостномозговое кроветворение в печени при анемии. По ходу синусоидой видны скоплении кроветворной ткани (1), в гепатоцитах - признаки жировой дистрофии (2).

Рис. 16. Малокровие почек при острой постгеморрагической анемии. Почки дряблой консистенции, с желтоватым оттенком.

При этих анемиях обнаруживают ряд дополнительных признаков. Общими для них являются гемосидероз и гемолитическая желтуха. При внесосудистом гемолизе (чаще при наследственных аномалиях эритроцитов) гемосидерин откладывается в местах разрушения дефектных эритроцитов костном мозге, селезенке, печени; при внутрисосудистом гемолизе (иммунном, токсическом) - во многих внутренних органах, где имеются клетки, способные выполнять функции сидеробластов. Кроме того, при гемолизе, обусловленном генетическими дефектами структуры эритроцитов, в периферической крови, селезенке и костном мозге обнаруживают атипичные эритроциты - сфероциты, овалоциты, мишеневидные клетки и т. д. При перечисленных формах анемий могут быть вторичные нарушения эритропоэза, что усложняет клиническую и морфологическую картину. Так, при гемолитических анемиях гемопоэз может приобретать мегалобластические черты (из-за недостаточности фолата при гиперрегенерации эритрона). При хронической анемии, связанной с кровотечениями (маточными, язвенными, из опухолей и т. д. ) возникает дефицит железа – анемия становится железодефицитной.

В эту группу включены анемии, связанные с нарушением пролиферации и дифференцировки эритроидных клеток. Замедление пролиферации клеток костного мозга чаще касается не только эритроидного, но и других ростков гемопоэза снижается объем красного костного мозга с уменьшением количества всех гемопоэтических клеток. Аплазия гипопластическая (“гипоплазия”). -практически полное или отсутствие гемопоэтических апластическая анемия стровков. Реже встречаются изолированные дефекты пролиферации эритроидного ростка. Они могут быть связаны с нарушением продукции (рецепции) специфических факторов роста (эритропоэтина) или с генетическими дефектами родоначальных клеток.

Макроскопически кожа и внутренние органы резко бледные. В коже выявляют точечные кровоизлияния. Часты также инфекционные процессы на слизистых оболочках (главным образом желудочно кишечного тракта). Во всех костях скелета обнаруживают желтый костный мозг. Иногда видны мелкие красноватые участки очажки сохранившегося гемопоэза. При исследовании периферической крови определяется картина панцитопении. Ретикулоциты немногочисленны или отсутствуют. В костном мозге сохра няются в основном лимфоидные клетки. Нарушения регенерации, ведущие к апластической анемии, могут быть первым этапом неопластической трансформации. Таким образом, апластические состояния гемопоэза рассматриваются как предлейкоз. Иногда при исследовании трепанобиоптата у больного с панцитопенией обнару живают, что вес пространства костно мозговых лакун заняты опухолевыми клетками некостномозгового происхождения (например, рака молочной железы или легкого). Разрастание метастатической опухоли приводит к подавлению нормального гемопоэза панмиелофтизу. При этом клетки эпителиального происхождения проявляют десмопластические свойства способны стимули ровать пролиферацию соединительнотканных клеток и коллагеногенез. Возникает вторичный, иногда очень грубый фиброз ткани костного мозга.

Нарушение дифференцировки эритроидных клеток происходит при дефиците необходимых для этого веществ. Наибольшее значение имеют анемии при недостатке железа (железодефицитная анемия), витаминов В 12 и фолиевой кислоты (мегалобластные анемии). Железо входит в состав гема, при его недостатке нарушается процесс синтеза гемоглобина и включения его в состав эритроцитов. Железодефцитные анемии обычно возникают при хронической потере крови. Имеют значение также повышение потребности в железе, недостаток его в пище и нарушение всасывания. При всех обстоятельствах анемия развивается только после мобилизации железа из всех его депо. Макроскопически обращают внимание на состояния, способствующие дефициту железа (заболевания желудочно-кишечного тракта, резецированный желудок) и сопутствующие ему (изменения ногтей (койлонихия), атрофический глоссит). Эритроциты периферической крови бледные (гипохромны), с тенденцией к уменьшению в размерах (микроцитоз). Встречаются эритроциты разных размеров (анизоцитоз) и формы (пойкилоцитоз). В костном мозге самым важным признаком, указывающим на дефицит железа, является отсутствие как внутри, так и внеклеточных гранул гемоси-дерина (выявляются по голубому окрашиванию при реакции Перлса). Изменения гемопоэза не столь значительны. Может наблюдаться некоторая активация эритропоэза; количество базофильных и полихроматофильных нормобластов увеличено, а оксифильных - уменьшено.

Так называемую пернициозную анемию впервые описали Аддисон и Бирмер. Причины дефицита витамина В 12 Ø является снижение продукции "внутреннего фактора Касла" в слизистой оболочке желудка, что наблюдается при патологии желудка - при аутоиммунном гастрите (А) или после обширных резекций, Ø нарушение всасывания (при энтерите) и конкурентное потребление больших количеств витамина В 12 при инвазиях (в частности, дифиллоботриозе), Ø при алкоголизме, глютеновой энтеропатии, болезни Крона, после операций на желудочно-кишечном тракте Однако дефицит обоих факторов (витамина В 12 и фолата) вне зависимости от причины его развития оказывает на гемопоэз сходное влияние - нарушаются синтез ДНК и дифференцировка эритроидных и других клеток гемопоэза. Эритропоэз становится мегалобластическим.

Рис. 5. Атрофия слизистой оболочки желудка при пернициозной анемии. Слизистая оболочка желудка истончена (1), количество желез п теле желудка уменьшено, количество главных и париетальных клеток в фундальных железаx уменьшено. В собственной пластинке слизистой оболочки - склероз, выраженный диффузный лимфогистиоцитарный инфильтрат, местами формируются лимфоидные фолликулы (2).

Мегалобласты - это ядросодержащие эритроидные клетки, отличающиеся от нормобластов прежде всего задержкой созревания ядра. Процесс образования гемоглобина почти не нарушается, в результате степень гемоглобинизации в мегалобласте не соответствует степени созревания ядра Часть мегалобластов разрушается еще в костном мозге, разрушение эритроидных элементов в типичных случаях преобладает над их образованием (неэффективный гемопоэз). По мере углубления анемии прогрессирует гиперплазия костного мозга, особенно эритроидного ростка. Раннее разрушение большого числа незрелых и уменьшение продолжительности жизни зрелых клеток мегалобластического эритропоэза приводят к развитию гемолитической желтухи и гемосидероза. Поражения ЖКТ и нервной системы характерны для дефицита витамина В 12.

Рис. 4. Гемосидероз селезенки. Размеры органа незначительно увеличены, на разрезе селезенка темно-красная с вкраплениями бурого цвета.

• • Макроскопически кожа бледная, с лимонно-желтым оттенком. Внутренние органы, особенно селезенка, печень и почки с буроватым оттенком (гемосидероз). В тяжелых случаях встречаются кровоизлияния в слизистые и серозные оболочки. Костный мозг в губчатых костях малиново-красный, сочный, а в трубчатых костях имеет вид малинового желе. Слизистые оболочки органов желудочно-кишечного тракта атрофичны. Язык имеет своеобразный "лакированный вид". Атрофия слизистой оболочки желудка, как уже указывалось, является одной из причин болезни. Кроме того, развивается фуникулярный миелоз. При исследовании периферической крови и костного мозга обнаруживают признаки гиперплазии кроветворных клеток. Ядра мегалобластов крупнее, хроматин нежнее, чем у нормобластов, ядра имеют мелкоячеистую структуру в отличие от таковых грубодисперсного хроматина нормобластов, между глыбками которого имеются щелевидные просветления. Эритроциты увеличены в размере (макроциты), характерны пойкило- и/или анизоцитоз. В некоторых клетках присутствуют остатки ядерного материала - тельца Жолли. Ядросодержащие эритроидные клетки могут выходить в периферическую кровь, при этом количество ретикулоцитов в крови снижено. Лейкоэритробластическое отношение в костном мозге сдвигается в сторону эритропоэза. Эритроидные клетки занимают не менее 50 % площади костномозговых лакун. Структурные аномалии клеток (дисплазия) определяются во всех ростках кроветворения. Для миелоидных клеток (в том числе гранулоцитов) характерен гииорегенераторный сдвиг. Выявляются гигантские нейтрофилы с гиперсегментированными (более 5 сегментов) ядрами, гигантские мегакариоциты с ядрами неправильной формы и др. Число лейкоцитов и тромбоцитов в периферической крови уменьшено.

Это противоположные анемиям состояния, при которых повышается количество эритроцитов в периферической крови. Эти изменения происходят в рамках приспособительных реакций, например при хронической гипоксии (сердечная или легочная недостаточность), у жителей высокогорья и т. д. В костном мозге наблюдается умеренная гиперплазия эритроидного ростка без структурных аномалий клеток.

- это клональные новообразования, родоначальными клетками клона являются трансформированные стволовые или ближайшие к ним клетки. Периферические лимфоидные опухоли могут происходить из клеток, малигнизированных на этапах бласттрансформации. Большинство опухолей проходит 2 стадии: v моноклоновую с менее агрессивным биологическим поведением v поликлоновую, которая отражает опухолевую прогрессию. поликлоновую

Традиционный подход к классификации опухолей системы крови подразумевает выделение: первично-системных - лейкозов первично-локальных - гематосарком(миелосарком и лимфом) процессов. При лейкозах опухолевые клетки, в том числе лимфоидные, растут в костном мозге и, как правило, выходят в кровь. У больных с лимфомами в течение длительного времени единственным местом локализации опухоли может оставаться внекостномозговая лимфоидная ткань. Однако клетки однотипных лимфомы и лейкоза (например, лимфобластных или лимфоцитарных) совершенно идентичны по морфологическим, антигенным и генетическим параметрам. Поэтому соответствующие лимфома и лейкоз должны быть классифицированы как единая опухоль. Различия в поведении опухоли не являются абсолютными, это подтверждается частотой перехода локализованной опухоли в системную (так называемая лейкемизация лимфом). В то же время структура лимфатического узла у больного с лимфоцитарной лимфомой и хроническим лимфолейкозом одинакова. Миелосаркомы встречаются редко и чаще всего представляют собой кратковременный внекостномозговой старт острого лейкоза.

Рис. 14. Миеломная клетка. При электронной микроскопии в цитоплазме миеломной клетки обнаруживается большое количество резко расширенных канальцев эндоплазматической сети, заполненных парапротеином. Ядро расположено эксцентрично.

Рис. 6. Бластная клетка при лейкозе. Патологический митоз c неравномерным распределением хроматина.

Рис. 7. Некроз миндалин при остром лейкозе. Миндалины увеличены, видны участки некроза серо-черного цвета. Перитонзиллярная ткань отечна, гиперемирована. На слизистой оболочке языка и зева имеется множество точечных кровоизлияний.

1) степени коммитации клетки - родоначальницы клона, т. е. широты возможных направлений ее дифференцировки; 2) степени сохранения способности к созреванию. Именно сохранение способности трансформированных клеток к дифференцировке лежит в основе классификации лейкозов на острые и хронические. Если опухолевые клетки такую способность утратили, то опухоль состоит из бластов с очень небольшой примесью зрелых кроветворных клеток. Если промежуточные формы отсутствуют, то такое состояние называют лейкозным провалом. Если созревание опухолевых клеток происходит, то лейкоз обозначают как хронический. При этом в костном мозге и крови обнаруживаются клетки на всех стадиях дифференцировки от бластов до зрелых форм. Морфологическим проявлением лейкозов служит разрастание атипичных кроветворных клеток в костном мозге, селезенке, лимфатических узлах, затем в факультативных кроветворных органах (печени, почках) и, наконец, в строме остальных органов (лейкозные инфильтраты). В основе выбора ткани для внекостномозговой пролиферации лежат особенности микроокружения, с которым встречаются лейкозные клетки, перенесенные в орган-мишень током крови или лимфы, а также способность микроокружения поддерживать пролиферацию и дифференцировку опухолевых клеток. Пролиферация опухолевых клеток в негемопоэтических тканях (кожа, оболочки мозга и др. ) отражает обычно поликлоновую трансформацию и соответствует терминальным стадиям болезни. Атипичные клетки, как правило, в больших количествах поступают в кровь (иногда до сотен × 10 9/л - лейкозный вариант). В некоторых случаях костномозговой барьер оказывается непроницаем, тогда в периферической крови лейкозных клеток нет (алейкозный вариант). Разрастающиеся клетки обычно не разрушают органы и не прорастают в окружающие ткани

В основу современной классификации опухолей миелоидной и лимфоидной тканей (ВОЗ, 1999) положен принцип гисто(цито)генеза, т. е. тканевого (клеточного) происхождения. В раздел "Опухоли миелоиднои ткани" включены: • острые миелоидные лейкозы; • миелодиспластический синдром; • миелопролиферативные заболевания (хронические лейкозы) В раздел " Опухоли лимфоидной ткани" включены: • В-клеточные опухоли (в том числе лейкозы и соответствующие им лимфомы); • Т-клеточные опухоли (в том числе лейкозы и соответствующие им лимфомы); • лимфома Ходжкина (лимфогранулематоз).

Клинико-морфологические проявления опухолей системы крови обусловлены неконтролируемой пролиферацией клеток, а выделение ими медиаторов или токсинов (при распаде) определяет изменения тканей за пределами опухоли. При поражении костного мозга происходит подавление роста нормальных клонов гемопоэтических клеток (недостаточность костного мозга). При пролиферации опухолевых клеток во внутренних органах возникают дистрофия и атрофия их паренхимы. Описанные изменения практически исчерпывают перечень важнейших причин смерти таких больных. Принадлежность опухолевых клеток миелоидного типа к определенному ростку кроветворения не всегда идентифицируется при светооптическом исследовании. Обычно для этих целей используют методы определения активности ферментов и концентрации субстратов (гистохимическое исследование на пероксидазу, кислую фосфатазу, эстеразу, гликоген, жир). В сложных случаях применяют электронную микроскопию. Уровень дифференцировки в большинстве случаев определить проще, так как в ходе дифференцировки существенно меняется структура клеток. В последнее время для решения этих вопросов стало возможным использовать иммуногистохимическое исследование с выявлением дифференцировочных антигенов отдельных клеточных линий. Диагностика лимфоидных опухолей требует обязательного определения иммунофенотипа опухолевых клеток.

Современная классификация миелопролиферативных заболеваний основывается на определении клеточного состава опухолевых пролифератов, причем преждевсего учитывают их принадлежностьк определенному ростку кроветворения и уровень дифференцировки. Значительное место в классификации делено генотипу опухоли.

Они составляют более 85 % острых лейкозов у взрослых. Макроскопически костный мозг губчатых и трубчатых костей красный, иногда сероватый или зеленоватым ("пиоидный"). Печень, селезенка и лимфатические узлы увеличены, но значительных размеров не дос тигают. В полости рта, зеве, желудке и кишечнике часто обнаруживают язвенно некротические изменения. Почки или диффузно увеличены, или с очаговыми разрастаниями в виде узелков. Очаги саркомопо добного роста могут встречаться и в других органах. Резко выражены явления геморрагического диатеза. При монобластном лейкозе часты гиперпластически язвенные поражения десен. При микроскопическом исследовании опухолевых пролифератов с при менением дополнительных методов морфологического и генетического анализа определяют место опухоли в классификации острых лейкозов. В отдельную группу включены варианты острого миелоидного (миело- бластного) лейкоза, характеризующиеся стойкими цитогенетичес-кими аномалиями, в частности острый миелоидный лейкоз с транс-локацией (8; 21), указывающей на относительно благоприятный прогноз, а также острый промиелоцитарный лейкоз t(15; 17). Опухолевые клет ки имеют сходство с промиелоцитарный содержат большое коли чество гранул, в том числе палочки Ауэра.

Остальные лейкозы этой группы классифицированы в соответствии с критериями FAB (1982). Выделяют острый миелоидный лейкоз с минимальной дифференцировкой. При нем опухолевая ткань состоит из бластов с отрицательной реак цией на пероксидазу и отсутствием каких либо других цитологических и цитохи мических признаков миелоидного происхождения. Ультраструктура клеток соот ветствует таковой миелобластов. Клетки экспрессируют антигены миелоидной линии. q При остром миелоидном лейкозе без созревания в опухолевой ткани преобладают бласты (более 90 % неэритроидных клеток) без цитологических признаков дифференцировки; более 3 % из них содержат пероксидазу. Отдельные клетки имеют азурофильную зернистость в цитоплазме и тельца Ауэра. q При остром миелоидном лейкозе с созреванием обнаруживают 20 90 % бластных клеток с признаками миелоидной дифференцировки, в опухоли менее 20 % моноцитов. q При остром миеломоноцитарном (миеломонобластном) лейкозе бласты составляют более 20%, моноциты и предшественники более 20%. Имеются явные признаки гранулоцитарной и моноцитарной дифференцировки опухолевых клеток. Встречается значительное количество моноцитов и их предшественников с положительной реакцией на эстеразу. q При остром моноритарном (монобластном) лейкозе наблюдается резкое преобладание монобластов. q При остром эритроидном (эритробластном, эритромиелобластном) лейкозе опухолевые клетки представлены миелобластами и эритробластами. Обнаруживается не менее 20% бластов среди неэритроидных элементов. q При остром мегакариоцитарном (мегакариобластном) лейкозе в опухолевой ткани выявлено не менее 30 % мегакариобластов.

Этот термин объединяет клональные нарушения гемопоэза, которые характеризуются цитопенией в периферической крови и дисплазией костного мозга. При этом количество миелобластов может быть увеличено (до 5% в периферической крови и до 20 % в костном мозге). Цитопения не поддается терапии и может привести к смерти. Кроме того, в исходе часто (8 -60 % случаев при разных формах) развивается острый миелоидный лейкоз. Дети болеют реже, чем взрослые, но частота трансформации в острый миелоидный лейкоз у детей выше. В периферической крови анемия; размеры эритроцитов нормальные или увеличены (макроцитоз). В тяжелых случаях наблюдаются анизо- и пойкилоцитоз. Количество ретикулоцитов нормальное или снижено. Часто встречаются нейтропения и тромбоцитопения. Количество гранул нейтрофилов может быть уменьшено, или гранулы не определяются при гематологических окрасках. Тромбоциты могут быть гигантскими. В костном мозге число клеток увеличено или нормальное. Черты клеточной атипии (дисплазии) определяются во всех ростках гемопоэза. В эритроидных клетках имеются "почкующиеся" ядра (с полициклическими контурами), гранулы гемосидерина могут в виде кольца окружать ядро ("ringed sideroblasts"), часто возникает мегалобластоидная трансформация эритропоэза. Гранулоциты двуядерные либо с двудольчатыми ядрами, цитоплазма базофильная и/или вакуолизирована. Количество вторичных гранул снижено. Активность миелопероксидазы снижена, эстеразы - повышена. Мегакариоциты малых размеров (микромегакариоциты) полиморфны - от многоядерных мегакариоцитов с изолированными ядрами до клеток с однодольчатым ядром. Признаки тканевой дисплазии заключаются в аномальной локализации незрелых клеток миелопоэза. Миелобласты (часто группами) располагаются в центральных отделах лакун костного мозга (а не паратрабекулярно, как в норме).

Это опухоли миелоидного ростка костного мозга, развивающиеся из трансформированных клеток – предшественников миелопоэза. Дифференцировка клеток не блокирована, поэтому опухолевая ткань состоит из как незрелых, так и зрелых клеток трех ростков миелопоэза - гранулоцитарного, эритроцитарного и мегакариоцитарного. Зрелые клетки преобладают. При длительном течении миелопролиферативных заболеваний развивается фиброз костного мозга. Другим исходом является вторичный острый (как правило, миелоидный) лейкоз (при хроническом миелолейкозе это состояние называют (постным кризом). На основании преобладания в опухоли клеток тех или иных ростков миелопоэза и времени развития фиброза различают4 основных варианта этих болезней, проявления которых во многом перекрывают друга.

• имеет наибольшее значение среди миелопролиферативных заболеваний. В отличие от других миелопролиферативных заболеваний, хронический миелолейкоз характеризуется стойкой (более 90 % больных) генетической аномалией 1(9, 22) (филадельфийская хромосома), которая приводит к появлению гибридного гена bcr-abl. Стадии: 1 - начальная, 2 - развернутых проявлений, 3 - акселерации, 4 - бластный криз. Начиная со стадии развернутых проявлений, макроскопически обнаруживают гиперплазию костного мозга губчатых и трубчатых костей, костный мозг становится серо-красным или зеленоватым ("пиоидный"). Кровь серо-красная, органы малокровны. Селезенка и печень резко увеличены в размерах (масса селезенки может превышать нормальную в 50 раз). На разрезе селезенка темно-красная, часто с инфарктами. Печень серо-красная (серо-коричневая), часто желтоватая (жировая дистрофия). Объем лимфатических узлов и лимфоидной ткани слизистых оболочек увеличивается незначительно. Лимфатические узлы мягкие, серо-красные. В терминальной стадии могут выявляться очаги саркоматозного роста (лейкемиды) в коже и оболочках мозга.

• В крови число лейкоцитов превышает 100 х 109/л. Выражен сдвиг до миелоцитов и промиелоцитов. Часто в значительном количестве присутствуют эозинофильные и базофильные гранулоциты. Число тромбоцитов повышено. • Костный мозг исключительно богат клетками. Жировые клетки почти полностью вытеснены. Выражена трехростковая пролиферация с преобладанием гранулоцитарного ростка. Имеются очаговые скопления мегакариоцитов, в том числе мелких диспластичных. Структура нейтрофилов почти нормальная, однако, содержание миелопероксидазы в них может быть снижено, а щелочная фосфатаза обычно полностью отсутствует (при лейкемоидных реакциях активность щелочной фосфатазы очень высокая). В терминальной стадии резко возрастает число властных клеток. Количество зрелых клеток уменьшается (недостаточность костного мозга). Чаще всего (более 70 % случаев) властные клетки имеют морфологические, цитохимические и антигенные маркеры миелобластов, в других случаях - лимфобластов.

Рис. 8. Головной мозг при остром миелобластном лейкозе. В просветах мелких сосудов видны скопления недифференцированных лейкозных клеток. Опухолевые клетки инфильтрируют стенки сосудов и прилежащую ткань головного мозга на (1). Очаг кровоизлияния (2).

В сосудах внутренних органов выявляются скопления лейкозных клеток. В печени инфильтраты располагаются по ходу синусоидов, в селезенке - в красной пульпе. В других органах - тромбозы, кровоизлияния. Почка может быть подагрической (вследствие гиперурикемии при массивном распаде опухолевых клеток).

Рис. 10. Селезенка при хроническом миелолейкозе. Размеры селезенки увеличены, капсула гладкая, на разрезе темнокрасного цвета, видны белые очаги (ишемические инфаркты).

Рис. 11. Печень при хроническом миелолейкозе. По ходу синусоидов и в меньшей степени в портальных фактах видны скопления опухолевых миелоцитов (1). Гепатоциты с признаками жировой дистрофии и липофусциноза (2).

Рис. 12. Лимфатические узлы при хроническом лимфолейкозе. Лимфатические узлы увеличены, местами граница между ними сохранена.

Рис. 9. Костный мозг при хроническом миелолейкозе. Костный мозг плоских и трубчатых костей зеленовато-серого цвета ("пиоидный")

Это миелопролиферативные заболевания, которые на первых стадиях развития сопровождаются выраженным эритроцитозом в периферической крови и относительно запаздывающими во времени тромбоцитозом и нейтрофилезом. Филадельфийская хромосома отсутствует. Важнейший признак, позволяющий отличить истинную полицитемию от вторичных эритроцитозов, - отсутствие эритропоэтина в крови. Макроскопически костный мозг в состоянии гиперплазии. Все органы и ткани резко полнокровны. В сосудах встречаются тромбы, в органах инфаркты. Часто имеется гипертрофия левого желудочка сердца. Селезенка и печень увеличены, особенно значительно при развитии фиброза костного мозга (на поздних стадиях болезни). При микроскопическом исследовании в костном мозге обнаруживают разрастание клеток всех ростков миелопоэза. Относительно рано возникает ретикулиновый, а затем и коллагеновый фиброз. При развитии выраженного фиброза опухолевая ткань разрастается в селезенке и печени.

Особенностью этого миелопролиферативного заболевания является стимуляция опухолевыми клетками фибробластов костного мозга с возникновением выраженного реактивного фиброза. Макро- и микроскопическая картина зависит от стадии процесса. Заболевание начинается с пролиферации всех ростков миелопоэза, но особенно - мегакариоцитов. В дальнейшем нарастает фиброз костномозговых лакун, при этом в тяжах соединительной ткани длительно сохраняются очаги гемопоэза, в которых по-прежнему преобладают мегакариоциты. Одновременно с уменьшением объема костномозговых пространств опухолевая миелоидная ткань разрастается в селезенке и печени, что приводит к прогрессивному увеличению их размеров.

Это заболевание встречается реже. Преобладает гиперплазия мегакариоцитов, что сопровождается продукцией большого количества тромбоцитов. В периферической крови умеренно увеличено содер-жание лейкоцитов. Количество тромбоцитов может превышать в 5 раз и более нормальные показатели. Тромбоциты разных размеров, много гигантских форм. Костный мозг имеет признаки небольшой или умерен-ной гиперплазии. Резко увеличено содержание мегакариоцитов. Они полиморфны, многие гиган-тских размеров. Несколько повышено число рети-кулиновых волокон. Разрастание соединительной ткани никогда не достигает такой степени, как при миелофиброзе.

В основу классификации ВОЗ (1999) лимфом положена пересмотренная Европейско-американская классификациялимфоидных опухолей (REAL, 1994). По морфологическим и клиническим признакам лимфома Ходжкина (лимфогранулематоз) в большинстве случаев резко выделяется из группы лимфом. По отношению к В- и Т-клеточным опухолям допустимоприменять термин "неходжкинские лимфомы". Классификация лимфом строится на основе определения иммунофенотипа опухолевых клеток и (по возможности) морфологического и антигенного сходства с нормальными аналогами. Большинство (до 85%) неходжкинских лимфом представляет собой В-клеточные опухоли. Опухолевая природа лимфоидного пролиферата может быть доказана при иммуногистохимическом или молекулярно-генетическом исследовании. Перестройка генов иммуноглобулинов и рецепторов Т-клеток в ходе нормальной дифференцировки в большинстве опухолей предшествует опухолевой трансформации. Клетки опухо-левого клона, следовательно, несут одинаковые рецепторы или иммуноглобулины. Их выявление доказывает клональность пролиферата и таким образом его опухолевую природу. Опухолевые В- и Т-лимфоциты в лимфоидных органах обычно занимают ниши, свойственные их нормальным аналогам.

Рис. 13. Печень при хроническом лимфолейкозе. В портальных трактах массивные скопления опухолевых клеток лимфоидного ряда (1). Гепатоциты с признаками жировой дистрофии и липофусциноза (2).

Опухоли из предшественников В-и Т-клеток. К этой группе относятся лимфобластные лимфомы/лейкозы. Опухоли из лимфоидных предшественников встречаются у детей значительно чаще, чем у взрослых. Среди лейкозов до 85% приходится на npe-B-клеточные опухоли, среди лимфом до 70 % - на пре-Т-клеточные. Большинство лимфом этого типа локализуется в средостении. Лимфобластные лимфомы (независимо от фенотипа) склонны к быстрой лейкемизации. Макроскопически костный мозг губчатых и трубчатых костей малиновокрасный, сочный. Селезенка, лимфатические узлы, лимфоидные узелки слизистых оболочек, тимус, а также почки увеличены. Селезенка сочная, красная на разрезе, рисунок ее стерт. Лимфатические узлы резко увеличены, на разрезе ткань их бело-розовая, сочная. Разрастания опухолевой ткани также обнаруживаются в оболочках мозга, яичках и т. д. В крови преобладают бластные клетки. Микроскопически опухолевая ткань представлена однотипными бластными клетками с нежной структурой хроматина, ядрышки неяркие или отсутствуют. В опухолевых клетках нет пероксидазы, имеются PAS(ШИК)-положительные гранулы.

Периферические В-клеточные лимфомы. В-клеточный хронический лимфолейкоз/лимфома из малых лимфоцитов. Среди лимфом это одна из самых "доброкачественных" опухолей. Иногда встречается ее трансформация в В-клеточные опухоли с более агрессивным течением. Макроскопически костный мозг губчатых и трубчатых костей красный, но в нем можно видеть желтоватые участку. Лимфатические узлы всех локализаций увеличены и сливаются в пакеты. Их консистенция мягкая или плотноватая. На разрезе ткань серо-розовая, сочная. Также выглядит лимфоидная ткань прочих локализаций. Селезенка резко увеличена (но меньше, чем при хроническом миелоидном лейкозе), мясистая, красная на разрезе. Печень и почки увеличены. На поверхности печени иногда определяются небольшие светлые узелки. В крови абсолютный лимфоцитоз. Даже если количество лимфоидных клеток в крови достигает очень высоких цифр (50 -70 х 10 у/л и более), признаки анемии и тромбоцитопении часто отсутствуют. При приготовлении мазков опухолевые клетки легко повреждаются, что приводит к своеобразному артефакту - появлению "смазанных (smudge) клеток" (теней Гумпрехта). Микроскопически опухолевая ткань представлена малыми лимфоцитами. Имеется примесь более крупных клеток, часть которых содержит центральное ядрышко (пролимфоциты). Последние местами образуют скопления - "пролиферативные центры". В случаях пролимфоцитарных лейкозов/лимфом эти клетки преобладают. Иммунофенотип: клетки содержат В-клеточные антигены CD 19, 20+; CD 79 a+, CD 5+, CD 23+.

§ Лимфоплазмоцитарная лимфома (иммуноцитома). Опухоль состоит из малых лимфоцитов, плазмоцитоидных лимфоцитов и плазмоцитов. В лимфатических узлах опухоль обычно растет между фолликулами, не повреждая синусы. Иммуноцитома соответствует так называемой макроглобулинемии Вальденстрема. Иммунофенотип: В-клеточных антигенов нет, имеются цитоплазматические иммуноглобулины, CD 5 -, CD 10 -. § Плазмоклеточная миелома/плазмоцитома. Опухоль состоит из клеток, которые напоминают зрелые или незрелые плазматические клетки, диффузно поражает костный мозг или формирует очаги (нередко множественные) в костях. Чаще всего локализуется в позвоночнике. В большинстве случаев в крови определяется большое количество иммуноглобулинов, в моче -легкие цепи иммуноглобулинов (белок Бенс-Джонса). Опухоль часто осложняется развитием амилоидоза (AL). Иммунофенотип: клетки содержат иммуноглобулины в цитоплазме, большинство В-клеточных антигенов не выявляется, CD 79 a+, CD 38+, ЕМА—/+.

• Экстранодальные лимфомы MALT-типа. Опухоли локализуются в лимфоидной ткани, ассоциированной со слизистыми оболочками. Опухоль представлена разно-образными клетками - центроцитоидными (клетки марги-нальной зоны), моноцитоидными В-лимфоцитами, малыми лимфоцитами и плазматическими клетками. Встречаются от-дельные крупные клетки типа центро- или иммунобластов. В эпителиальных органах (слизистые оболочки, слюнные железы и др. ) опухолевые клетки обычно инфильтрируют эпителий, формируя так называемые лимфоэпителиальные поражения. Иммунофенотип: опухолевые клетки содержат поверхностные иммуноглобулины. В-клеточные антигены, отсутствуют CD 5, CDIOh CD 23. • Фолликулярная лимфома. Опухоль составляет 45 % лимфом взрослых в США. В Европе встречается значительно реже. Опухоль представлена смесью центроиитов и центробластов в различных пропорциях. Полагают, что она происходит из клеток фолликулярного центра. Тип роста диффузный или нодулярный (фоллику-лярный). Иммунофенотип: клетки содержат поверхностные иммуноглобулины, В-клеточные антигены, обычно CD 10 и CD 23, нет CD 5. При фолликулярном росте экспрессия bcl-2 позволяет доказать опухолевый характер фолликулов.

Рис. 16. Лимфатический узел при лимфогранулематозе. Рисунок строения лимфатического узла стерт, лимфоидная ткань вытеснена клетками, среди которых определяются крупные одноядерные клетки Ходжкина (1) и многоядерные клети Березовского-Штернберга (2). Видны лимфоциты, плазматические клетки, эозинофилы, нейтрофилы (3).

Фолликулярная лимфома

Селезенка при фолликулярной лимфоме

§ Лимфома из клеток мантии. Опухоль состоит из клеток мелких и средних размеров. Хроматин в ядре более дисперсный, чем у зрелых лимфоцитов. Ядра неправильной формы, цитоплазма в виде небольшого светлого ободка. Опухоль растет диффузно с вовлечением мантийных зон фолликулов. Характеризуется агрессивным течением. Иммунофенотип: поверхностные иммуноглобулины (М), В-клеточные антигены, CD 5 + , CD 10 -, CD 23 -, Cyclin D 1+. § Диффузная крупноклеточная В-клеточная лимфома. Опухоль состоит из крупных клеток, имеющих структуру иммуно- или центробластов. Характеризуется агрессивным течением. Иммунофенотип: экспрессированы В-клеточные антигены. § Лимфома Беркитта. Опухолевые клетки мономорфны, с округлыми ядрами, многочисленными (до 5) ядрышками, относительно широкой базофильной цитоплазмой. Типична картина "звездного неба", которая создается многочисленными макрофагами с обильной цитоплазмой, находящимися среди опухолевых клеток. Опухоль исключительно агрессивна.

Периферические Т-клеточные лимфомы. Важнейшими среди них являются грибовидный микоз и анапластическая крупноклеточная лимфома CD 30+. • Грибовидный микоз. Опухоль локализуется в коже и состоит из мелких клеток с церебриформными ядрами. Клетки инфильтрируют эпидермис, формируя внутриэпидермальные скопления, растут также в паракортикальной зоне региональных лимфатических узлов. Опухоль развивается в течение многих лет. Возможна трансформация в более агрессивные формы. Иммунофенотип: Т-клеточные антигены (CD 2, CD 3, CD 5); в большинстве случаев опухолевые клетки экспрессируют CD 4. • Анапластическая крупноклеточная лимфома CD 30+. Опухоль состоит из крупных клеток с причудливыми (подковообразными и др. ) ядрами и многоядерных клеток. Клетки этой опухоли значительно крупнее клеток крупноклеточных В-лимфом и имеют обильную цитоплазму. Опухоль характеризуется агрессивным течением.

• Лимфома Ходжкина (лимфогранулематоз) обычно развивается в лимфатических узлах шеи или средостения. Опухоль распространяется лимфогенно и гематогенно сначала в соседние, затем в отдаленные от места первичной локализации лимфатические узлы. Позднее поражаются селезенка, костный мозг, печень и другие органы. Стадию болезни определяют на основании оценки распространенности поражения лимфоидных, гемопоэтических и других органов. Макроскопически пораженные лимфатические узлы резиновой плотности, на разрезе серовато-розовые, могут быть четко или не вполне четко очерчены, в ряде случаев очень плотные. Микроскопическая картина зависит от формы заболевания. Опухолевыми являются клетки двух типов: клетки Рида. Штернберга (в отечественной литературе Березовского. Штернберга) и клетки Ходжкина.

Рис. 15. Селезенка при лимфогранулематозе. Селезенка увеличена в размере, на разрезе красно-коричневая паренхима органа замещена желтовато-белой опухолевой тканью, формирующей отдельные очаги или разрастания неправильной формы.

Лимфогранулематоз. Клетки Березовского – Штернберга.

Клетки Рида-Штернберга крупные, с двумя ядрами (или двулопастным ядром)- ядра (лопасти) имеют зеркальный вид (симметричны), часто с инвагинациями ядерной мембраны на обращенных друг к другу поверхностях, в них есть довольно крупные оксифильные ядрышки, напоминающие включения и окруженные зоной просветления. Цитоплазма клеток амфофильна (окрашивается и основными, и кислыми красителями). Такие клетки называются диагностическими. Выделяют также варианты клеток Рида-Штернберга: 1. лимфогистиоцитарные со светлым, неправильной формы ядром (в форме ступни слона, жареных кукурузных зерен и т. д. ) и 2. лакунарные с вакуолизированной "поджатой" цитоплазмой. Кроме того, в опухоли встречаются гигантские многоядерные клетки разнообразной структуры. Клетки Ходжкина одноядерные, крупные, с крупным светлым ядром и крупным ядрышком, напоминающим включение. Считают, что для диагностики лимфогранулематоза необходимо обнаружение диагностических клеток. Особенностью опухоли является значительное количество клеток реактивной популяции: малых лимфоцитов, гистиоцитов, плазмоцитов, эозинофилов. Иммунофенотип опухолевых клеток относительно стабилен и включает положительные реакции на CD 30 и CD 15; реакции на В- и Т- клеточные антигены, CD 45 (LCA) и ЕМА отрицательные.

Классическая лимфома Ходжкина. • • Выделяют 4 варианта этой опухоли. Классический вариант с большим количеством лимфоцитов. Рост опухоли диффузный. Опухоль содержит небольшое количество диагностических клеток. "Фон" представлен большим количеством лимфоцитов, немногочисленными плазмоцитами и эозинофилами. Прогноз благоприятный. Нодулярный склероз. Рост опухоли (по крайней мере частично) нодулярный. Характерной чертой является разрастание соединительной ткани в виде тяжей, которые разделяют ткань на узелки. Опухолевые клетки имеют вид лакунарных. Встречаются также диагностические клетки. Реактивная популяция может включать в себя лимфоциты, гистиоциты, плазмоциты и эозинофилы. Иногда опухолевые узелки с типичными клетками содержат очень мало зрелых лимфоцитов. Однако эта особенность, по-видимому, не влияет на прогноз. В целом прогноз при этой форме благоприятный. Смешанно-клеточный вариант. Рост опухоли в основном диффузный. Определяется большое количество диагностических клеток Рида-Штернберга и их вариантов на "фоне" большого числа лимфоцитов, гистиоцитов, плазмоцитов и эозинофилов. Встречаются поля некроза, диффузный склероз. Течение умеренно агрессивное. Вариант с лимфоидным истощением. Рост опухоли диффузный, часто ткань выглядит малоклеточной из-за обширных полей некроза и склероза. Преобладают опухолевые клетки, в том числе атипичные многоядерные. Клетки реактивной популяции немногочисленны. Характерно агрессивное течение.

• Нодулярный вариант лимфомы Ходжкина с лимфоидным преобладанием. В последнее время его рассматривают отдельно. Это связано со значительными морфологическими, иммунофенотипическими и клиническими отличиями от классических вариантов. Данная опухоль обладает ноду-лярным типом роста. Опухолевые клетки имеют структуру "лимфогистиоцитарных" клеток с многолопастными несколько вздутыми ядрами. Диагностических клеток Рида-Штернберга нет. "Фоновую" популяцию составляют малые лимфоциты и гистиоциты. Другие клетки встречаются редко. Иммунофенотип опухолевых клеток противоположен иммунофенотипу клеток классической лимфомы Ходжкина: в "лимфогистиоцитарных" клетках не выявляется экспрессия ни CD 15, ни CD 30, в то же время атипические клетки экспрессируют CD 45 (LCA). В-клеточные антигены (CD 19, CD 20, CD 79 a) и ЕМА. У некоторых больных (5 %) нодулярный вариант лимфомы Ходжкина с лимфоидным преобладанием трансформируется в крупноклеточную В -клеточную лимфому.

анемии лекц.18.ppt